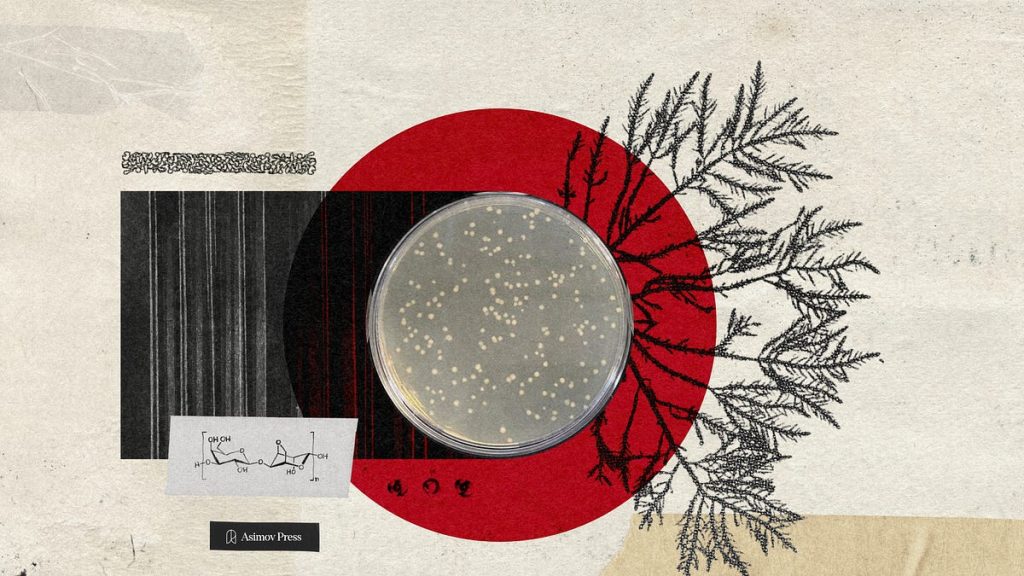
the-origins-of-agar

What it means that Ubuntu is using Rust
Righty-ho, I’m back from Rust Nation, and busily horrifying my teenage daughter with my (admittedly atrocious) attempts at doing an English accent. It was a great trip with a lot of good conversations and some interesting observations. I am going to try to blog about some of them, starting with some thoughts spurred by Jon […]
The First Fully General Computer Action Model

We designed FDM-1, a foundation model for computer use. FDM-1 is trained on videos from a portion of our 11-million-hour screen recording dataset, which we labeled using an inverse dynamics model that we trained. Our video encoder can compress almost 2 hours of 30 FPS video in only 1M tokens. FDM-1 is the first model […]
Hadrius (YC W23) Is Hiring Designers Who Code

This is a full-time role to be a Senior Product Designer, located onsite in New York, NY. Design @ Hadrius Like many other fields in tech, how design teams operate is shifting dramatically. That means Figma is being used less and less, while agents are being used more and more. Counter-intuitively though, this means that […]
An Introduction to the Codex Seraphinianus, the Strangest Book Ever Published

Imagine you could talk to Hieronymus Bosch, the authors of the Book of Revelation, or of the Voynich Manuscript—a bizarre 15th century text written in an uncrackable code; that you could solve centuries-old mysteries by asking them, “what were you thinking?” You might be disappointed to hear them say, as does Luigi Serafini, author and […]
A simple web we own
By R. S. Doiel, 2026-02-21 Tenant and product or co-owner and participant? Today the Web and Internet is owned and controlled by large for profit corporations and a few governments. Corporate ownership combined with government policies has left us as tenant and product. It has given us a surveillance economy and enshittification. What if I […]
Show HN: Sowbot – open-hardware agricultural robot (ROS2, RTK GPS)

Status: Largely fabricated/ constructed, ESP32 carrier needs some work A fully open-hardware robot compute unit built around a stackable 10 cm × 10 cm module standard with two Avaota A1 SIngle Board Computers (SBC) connected via a single ethernet cable. Board A: Control & Safety Board A is the primary controller responsible for the robot’s […]
Terence Tao, at 8 years old [pdf]
Download PDF
Julia: Performance Tips
In the following sections, we briefly go through a few techniques that can help make your Julia code run as fast as possible. Performance critical code should be inside a function Any code that is performance critical should be inside a function. Code inside functions tends to run much faster than top level code, due […]
Anthropic Education the AI Fluency Index

People are integrating AI tools into their daily routines at a pace that would have been difficult to predict even a year ago. But adoption alone doesn’t tell us much about the impact of these tools. A further, equally important question is: as AI becomes part of everyday life, are individuals developing the skills to […]
The Origins of Agar
Ella Watkins-Dulaney for Asimov Press. This essay will appear in our forthcoming book, “Making the Modern Laboratory,” to be published later this year. In 1942, at the height of British industrial war mobilization, an unlikely cohort scavenged the nation’s coastline for a precious substance. Among them were researchers, lighthouse keepers, members of the Royal Air […]